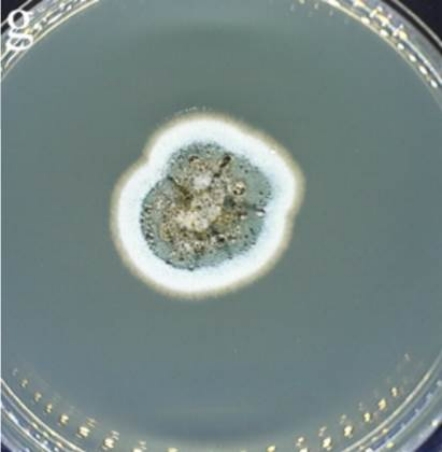

索引号:junanjnsd0122/2026-0000049
索引号:junanjnsd0122/2026-0000049 主题分类:卫生
主题分类:卫生  公开方式:主动公开
公开方式:主动公开 文号:
文号: 标题:
标题: 发布机构:莒南县卫生健康局
发布机构:莒南县卫生健康局 成文日期:
成文日期: 发布日期:2026-03-10
发布日期:2026-03-10 相关文件:
相关文件:
发霉的水果只要削掉霉点、煮熟就能放心吃了吗?
 打印
打印日常生活中,切除水果霉变部分后继续食用的现象较为普遍。这一做法虽源于节约习惯,但其潜在的食品安全风险不容忽视,因为霉变水果中可能会有潜藏的真菌及其产生的有害毒素。
一、霉变的微观真相:
看不见的“菌丝网络”
肉眼可见的霉斑,仅仅是霉菌发育成熟后的繁殖结构。当水果表面出现绒毛、粉末或色斑时,意味着真菌已经发育成熟并产生了大量孢子。而在其下方,真菌的营养菌丝早已像植物的根系一样,深入果肉内部吸收营养。这些菌丝通常无色透明,肉眼很难分辨。

图1 被真菌污染的水果
更大的风险在于真菌毒素。很多真菌在生长代谢过程中会分泌各类毒素,这些毒素通常易溶于水,水果中丰富的水分就成为了真菌毒素扩散的载体。这意味着,在霉斑周围看似正常的果肉中,很可能已经含有致病剂量的真菌毒素。
因此,鉴于水果的水分含量与物理质地极易协助毒素隐蔽扩散,仅凭霉斑大小无法准确界定食用安全边界。
二、水分——
真菌毒素扩散的加速器
水果中的水分不仅为霉菌生长提供了理想环境,更重要的是,它充当了溶剂和载体。一旦霉菌产生毒素(如展青霉素、链格孢毒素、赭曲霉毒素等),这些水溶性毒素极易溶解在水果组织间隙的游离水中,并随着水分在果实内部移动而快速渗透扩散。即使霉斑看上去只是局部的“一小块”,其产生的毒素也可能在水分的作用下,悄无声息地蔓延至肉眼看起来“完好无损”的果肉深处。
例证一:以质地相对致密的苹果为例,侵染它的扩展青霉会产生强水溶性的展青霉素。研究证实,即使切掉明显的霉斑,在距离霉斑数厘米外看似正常的果肉中,仍能检测到高浓度的毒素。展青霉素具有肾毒性,可导致肠道水肿,长期摄入更有致畸和致癌风险。

图2 青霉属菌落
例证二:对于番茄这类内部富含胶质水分的水果,一旦被链格孢属真菌感染,表皮出现黑色凹陷斑块,其产生的毒素(如链格孢毒素)会借助内部的液态介质迅速扩散。摄入此类毒素易引发呕吐、腹泻、腹痛等急性中毒,并可能干扰内分泌系统,存在潜在致癌风险。

图3 链格孢属菌落
例证三:草莓、葡萄等浆果组织松软、水分含量极高,极易被灰葡萄孢菌等穿透力强的霉菌侵染,导致果实迅速软烂。误食后可能引起恶心、腹泻等不适,其霉菌孢子还易飘散引发呼吸道过敏。
这些例子清晰地表明:霉变部位只是“冰山一角”,毒素的扩散范围远超肉眼所见。水果的质地虽然影响毒素初始渗透的速度,但由于高含水量的共性,一旦霉菌定植并产毒,毒素最终都有能力扩散至整个果实。
即便只是食用了那些已经切除霉变部分的“剩余好果”,实际上也仍然存在着摄入毒素的可能。
因此,为了有效规避急性食物中毒以及潜在的长期健康风险(如肝肾损伤、致癌性等),对于所有高水分含量的水果,一旦发现霉变,最安全的做法就是:坚决整颗(或整份)丢弃,切勿抱有侥幸心理继续食用。
实际上,确实存在极少数同时满足“水分极低”与“密度极高”条件的果蔬,典型代表为胡萝卜和青椒。由于这些果蔬具备致密的纤维结构且游离水含量极少,真菌菌丝与毒素难以在其中快速扩散。理论上,在霉斑周边多切除2-5厘米,剩余部分可能是安全的。
但在实际生活中,强烈建议不要冒险尝试!毕竟,普通人难以用肉眼精准判断病菌菌丝渗透的具体深度,且在切除过程中极易发生污染。
三、常规煮沸杀不死的
“顽固毒素”
很多人误以为“高温消毒”是万能的,认为食物发霉后只要彻底煮熟、烤透就能安全食用,其实这种观念存在一定程度的健康风险。
事实上,食物霉变后产生的真菌毒素种类繁多,其中许多具有极强的化学稳定性,常规的家庭烹饪方式,特别是简单的煮沸(通常不超过100℃),根本无法有效破坏或降解这些剧毒物质。
常见的危险真菌毒素包括:剧毒且强致癌的黄曲霉毒素;具有肾毒性和潜在致癌性的赭曲霉毒素A;主要污染玉米及其制品的伏马菌素;由禾谷镰刀菌产生、能引起剧烈呕吐的脱氧雪腐镰刀菌烯醇(俗称呕吐毒素,污染小麦、大麦、玉米等谷物);具有类雌激素作用、影响生殖系统的玉米赤霉烯酮;常见于腐烂苹果及其制品、具有神经毒性的展青霉素等等。这些都很难通过常规的煮沸来去除。
因此,一旦发现食物出现霉斑(如坚果干果上的黄绿色菌落)、长斑(如红薯上的褐色坚硬斑块)、变红(如甘蔗心部发红)、腐烂(如苹果)或变软、发芽(如土豆),务必牢记:任何常规的蒸、煮、炖、炸等加热过程,都无法保证消除其中潜藏的真菌毒素。
勤俭节约是中华民族的传统美德,也是对粮食的尊重。但是,节约的前提应是保障生活的健康与质量,而非增加潜在的致病风险。面对霉变果实,与其冒着生病的风险去“抢救”食品,不如给家人多一份安心。丢弃整份霉变食物绝非铺张浪费,而是对家人健康最切实的守护与负责。
(来源:健康淄博)
承办:莒南县人民政府办公室
网站标识符:3713270017 鲁ICP备06010595号
鲁公网安备37132702371333号


 智能问答
智能问答 无障碍
无障碍





 当前位置:
当前位置:



